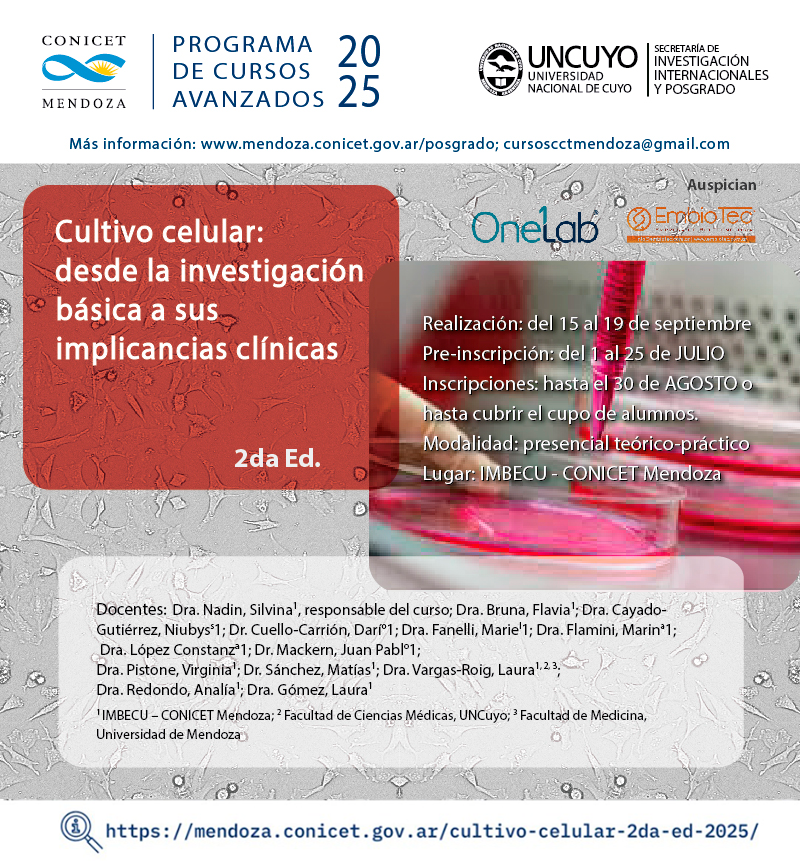
⚠️PRÓRROGA DE PREINSCRIPCIÓN⚠️

Más información👉  mendoza.conicet.gov.ar/cronograma-de-…

CONICET Mendoza
@conicetmendoza
Twitter oficial del Centro Científico Tecnológico CONICET Mendoza
ID: 3380204009
https://www.mendoza.conicet.gov.ar/ 17-07-2015 11:22:09
2,2K Tweet
2,2K Followers
1,1K Following




Búsqueda postulantes becas y/o prácticas profesionales ibam.conicet.gov.ar/3283-2/ IBAM-CONICET-UNCUYO CONICET Dialoga CONICET Mendoza